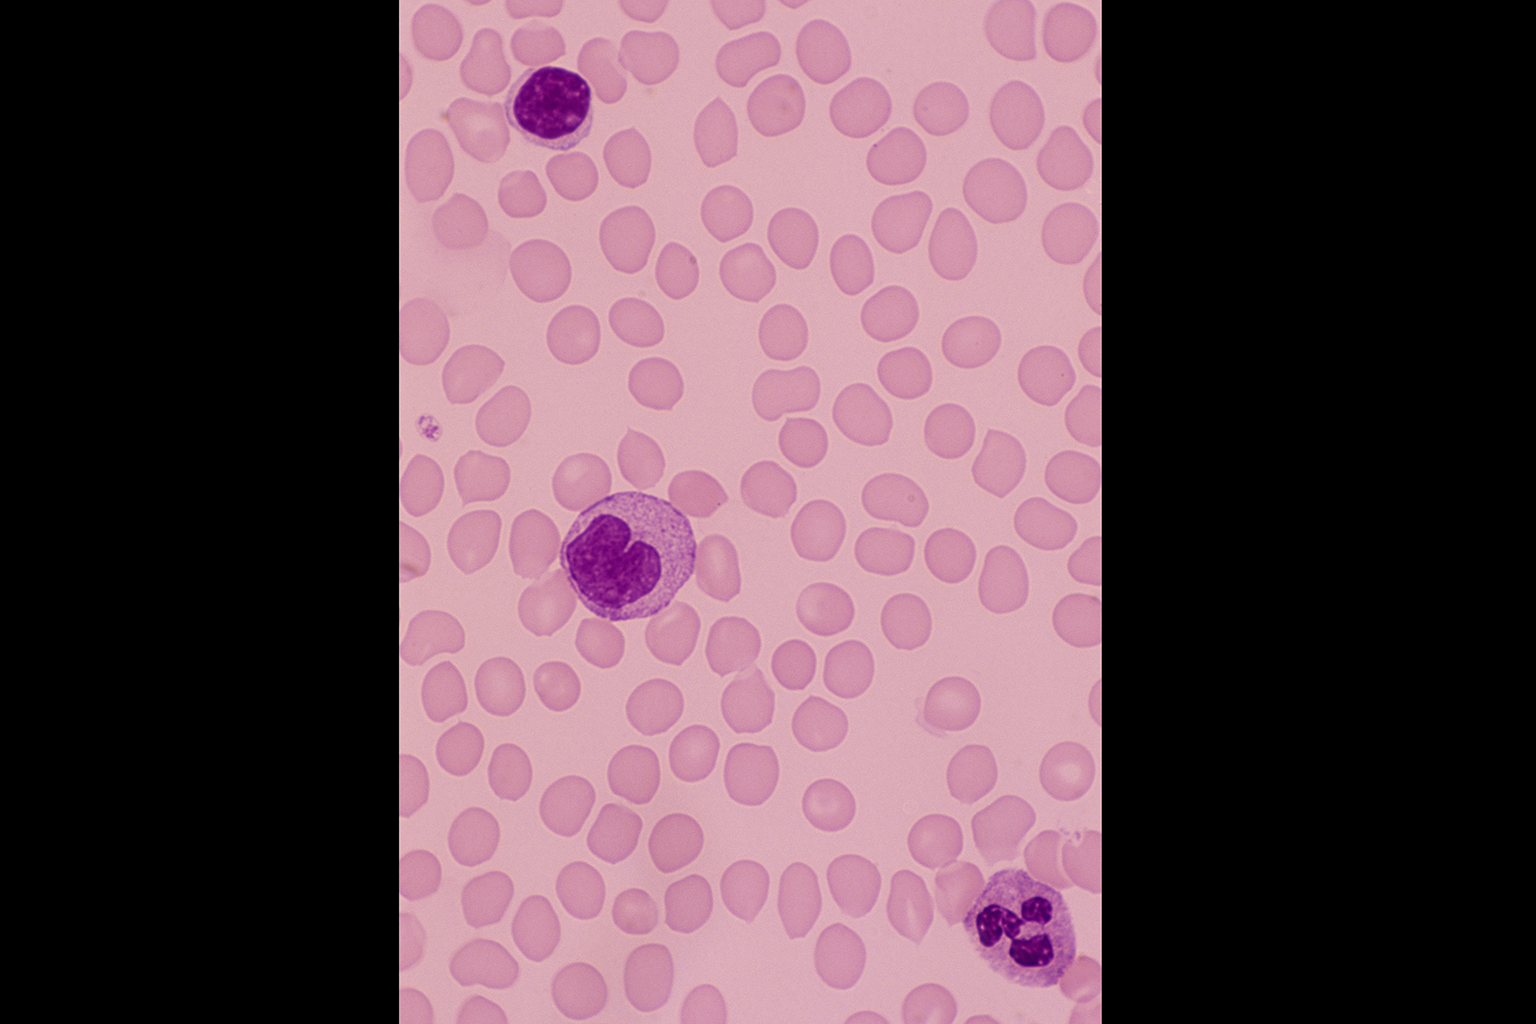

BRANDED CONTENT
Ask the Experts: Why is there a bump growing on my neck?
Dr Kevin Tay from OncoCare Cancer Centre explains what lymphoma is, the treatments available and how to live with this cancer
Sign up now: Get ST's newsletters delivered to your inbox

Although slow-growing lymphoma is often considered not curable, the majority of patients will continue to lead long and healthy lives. PHOTO: GETTY IMAGES
What are the symptoms of lymphoma and how is it diagnosed?
Lymphoma is a cancer that develops from white blood cells called lymphocytes. They are part of the immune system and are found mostly in the lymphoid organs such as the lymph nodes, spleen, bone marrow and tonsils.
There are more than 60 types of lymphoma, which can be categorised as either B- or T-cell lymphoma. They can be further classified as fast-growing (aggressive) or slow-growing (indolent) lymphoma.
In Singapore, lymphoma is the fifth most common cancer in males and sixth most common cancer in females.
In Singapore, lymphoma is the fifth most common cancer in males and sixth most common cancer in females.
Most people first notice an obvious lump or bump at their neck or lymph nodes, underarms or groin. Consult a family physician or general practitioner first for a check up.
Apart from usually painless lumps, other symptoms include a persistent low grade fever, persistent night sweats, or significant body weight loss within a few months. The presence of these symptoms usually warn of a poorer prognosis.
A biopsy of the affected area is done so the doctor can obtain a tissue sample to confirm the diagnosis and the lymphoma subtype.
Staging tests for lymphoma include a full body scan such as a positron emission tomography (PET) or computerised tomography (CT) scan to determine which areas are affected. A bone marrow biopsy is also needed to exclude involvement of the bone marrow site.
What are the risk factors of lymphoma?
The exact cause of lymphoma is unknown, but it has been associated with several risk factors. These include a history of autoimmune disease such as systemic lupus erythematosus (SLE), rheumatoid arthritis or Sjogren's disease. Certain infective agents such as the human immunodeficiency virus (HIV) and the hepatitis C virus are also associated with a higher risk of developing lymphoma.
People working in the oil and gas industry or a shipyard with chronic exposure to benzene over a long period are also at risk.
Can lymphoma be cured?
It depends on the type of lymphoma. Generally, fast-growing lymphoma is curable, with a 20 to 30 per cent chance of a relapse. The survival rate depends on the stage of the cancer, but about 70 to 80 per cent of patients will live more than five years.
And even though slow-growing lymphoma is often not considered curable, the majority of patients will continue to lead long and healthy lives. Not all patients with slow-growing lymphoma require chemotherapy; they may adopt a "watch and wait" approach.
Treatment for patients with slow-growing lymphoma is initiated when they exhibit symptoms that affect their quality of life, such as an enlarged neck mass compressing the airway and causing difficulty breathing.
Other reasons to begin chemotherapy include the lymphoma affecting other organ functions, or when the patient's blood test shows evidence of low blood count - suggesting the possibility of bone marrow involvement.
What are the treatment options available?
Chemotherapy is the main treatment method, and usually lasts for six months. Depending on the regimen of chemotherapy used, it is given once every three or four weeks. Radiotherapy is also an option for those who have minimal disease in one site.
With the advent of newer cancer therapies, patients now experience less toxicities.
Furthermore, there is also better supportive care treatment, such as more effective anti-nausea medications, in mitigating the side effects of chemotherapy.
Furthermore, there is also better supportive care treatment, such as more effective anti-nausea medications, in mitigating the side effects of chemotherapy.
One thing to note is that the risk of infection increases for those undergoing chemotherapy.
Patients should try to mitigate infections such as the common flu and maintain good hygiene. They should also drink fluids to prevent urinary tract infections, and watch what they eat to prevent food poisoning.
Patients should try to mitigate infections such as the common flu and maintain good hygiene. They should also drink fluids to prevent urinary tract infections, and watch what they eat to prevent food poisoning.
For more information on treatment options, click here.

Additional support available
It can be difficult for patients to keep track of and manage their medical records over the years as cancer treatment and follow-up is a long process. The OncoCare Connect (OCC Connect App) is part of the treatment journey, and helps patients manage their appointments, seek information and access medical reports more easily.
"We want to have a more collaborative doctor-patient relationship, where we encourage patients to participate in their care, manage their health condition, and increase understanding of their medical issues. We know that engaged patients have better outcomes," says Dr Tay.
